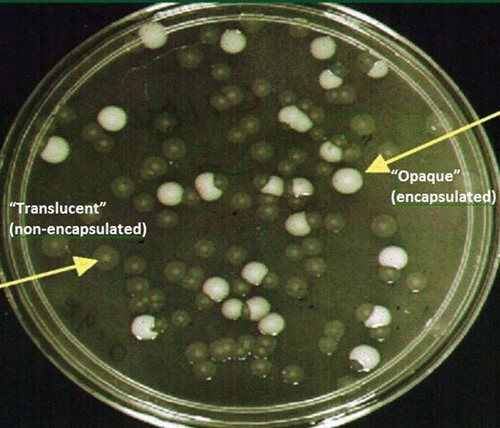
ASM tweet media

We did it!
Cytoscape Web v1.0 is live!
Try it here: web.cytoscape.org
Publication: doi.org/10.1093/nar/gk…
Manual: web-manual.cytoscape.org
#BiomedicalResearch #SystemsBiology
English
The NDEx Project
600 posts


@NDExProject
Developed @UCSanDiego, NDEx is an open source software infrastructure to store, share and publish biological network knowledge